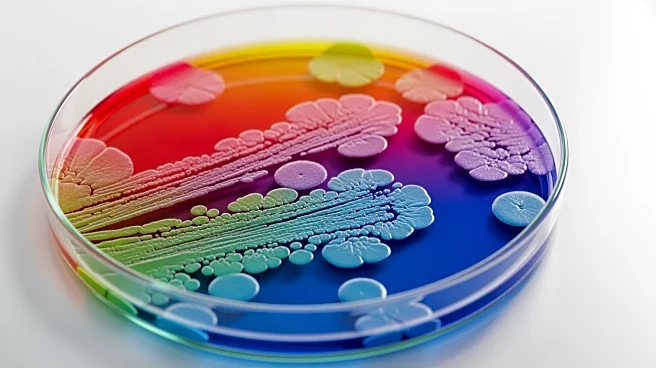
Study Identifies Microbes That Mitigate Peanut Allergy Reactions in Humans

What's Happening?
Chick-fil-A has decided to remove pea starch from its waffle fries recipe after receiving significant backlash from customers. The ingredient, added in late 2024, was intended to keep the fries crispier for longer. However, it proved unpopular among diners,
particularly those with food allergies. The removal of pea starch has been welcomed by many, with some customers expressing relief that their children with allergies can now enjoy the fries again. The change comes after numerous complaints and calls for the restaurant to revert to its original recipe.
Why It's Important?
The decision by Chick-fil-A to revert its waffle fries recipe highlights the impact of consumer feedback on product offerings in the fast-food industry. This move is significant for customers with allergies, as it allows them to enjoy the product without health concerns. It also underscores the importance of customer satisfaction in maintaining brand loyalty and market position. Fast-food chains often face challenges balancing innovation with customer preferences, and Chick-fil-A's response demonstrates a commitment to addressing consumer needs.